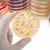
Nitrilotriacetic Acid

Acid Slurry - Liquid Form, 90% Purity, Brown Color | Technical Grade For Detergent Industry
Price: 100 INR / Liter
Get Latest Price
Minimum Order Quantity :
100 Liter
In Stock
Product Specifications
| Form | Liquid |
| Payment Terms | Cash Against Delivery (CAD), Cheque |
| Supply Ability | 1000 Per Week |
| Delivery Time | 1 Week |
| Packaging Details | as an industrial standard |
| Main Domestic Market | All India |
Product Overview
Key Features
Usage/Application: Detergent Industry
Form: Liquid
Color: Brown
Grade: Technical
Packaging Type: barrel
Company Details
Focusing on a customer-centric approach, Hans Traders has a pan-India presence and caters to a huge consumer base throughout the country. Buy Industrial Chemicals in bulk from Hans Traders at Trade India quality-assured products.
Business Type
Manufacturer, Supplier
Employee Count
3
Establishment
1979
Working Days
Monday To Sunday
Related Products
Explore Related Categories
More Products From This Seller
Seller Details
Ahmedabad, Gujarat
Proprietor
Mr. Janak J. Shah
Address
PLOT NO-3, VATVA ROAD, NAROL, OPPOSITE POST OFFICE, Ahmedabad, Gujarat, 382405, India
acid slurry in Ahmedabad
Report incorrect details